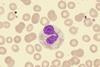
shutterstock_738912943 (1)

All Blood cancer articles
-
 News
NewsMerck expands haematology pipeline with $6.7bn acquisition of Terns Pharmaceuticals
Deal strengthens Merck’s oncology portfolio with addition of a potential best-in-class oral TKI for chronic myeloid leukaemia.
-
 News
NewsGilead adds to cell therapy portfolio with $8bn acquisition of Arcellx
Deal builds on the companies’ 2022 collaboration over CAR T therapy anito-cel.
-
 News
NewsNew technology could enhance CAR T therapy manufacture
The innovative device could improve CAR T cell cancer immunotherapy and facilitate its use as a first-line therapy, research suggests.
-
 News
NewsInnovative CAR T therapy could deliver in broader therapeutic settings, research suggests
The novel cell therapy utilises a shortened manufacturing process compared to standard production timelines, offering potential for enhanced therapeutic capability.
-
 News
NewsNICE recommends novel immunotherapy for leukaemia
The agency’s decision means eligible adult patients in the UK are set to access the combination immunotherapy as a new treatment option for acute lymphoblastic leukaemia (ALL).
-
 News
NewsASH 2024: CAR T-cell therapy demonstrates durable benefit in lymphoma
The cell therapy could increase survival in certain lymphomas without requiring patients to undertake subsequent therapy, the new analysis suggests.
-
 News
News‘Accidental’ media switch leads to CAR T therapy discovery
The investigators hope that their new approach could lead to large-scale manufacturing of the CAR T cells for blood cancer patients.
-
 Article
ArticleDrug approval roundup – May/June 2024
This article highlights some of the key regulatory approvals granted in May and June in the EU and US so far this year, including for oligonucleotide and biologic therapies.
-
 News
NewsFirst-in-class telomerase inhibitor approved for blood cancer
The FDA’s regulatory approval of the telomerase inhibitor is welcome, considering the high unmet need for many lower-risk myelodysplastic syndromes (LR-MDS) patients, according to Geron.
-
 Article
ArticleAdvancing targeted treatments for multiple myeloma
Edmond Chan, Senior Director, EMEA Therapeutic Area Lead, Haemato-Oncology, Johnson & Johnson Innovative Medicines, offers insight into the promising evidence of cell therapies and biologic-based treatments for patients with multiple myeloma.
-
 News
NewsImproving stem cell transplantation success in high-risk blood cancers
The new medicine is expected to enable over 99 percent of people from a wide range of racial/ethnic groups to find a donor, research says.
-
 Article
ArticleProgressing personalised cell therapies in oncology
Dr Imran Khan, PhD, Vice President, Medical Affairs, Hematology, Johnson & Johnson Innovative Medicine discusses the major benefits and current challenges of CAR-T cell therapies, as well as the potential of the company’s novel BCMA-targeted treatment for multiple myeloma.
-
 News
NewsCRISPR technologies fuelling haematological innovations
Greater use of CRISPR-based therapies in clinical trials is expected to drive further advancements in precision medicine, GlobalData states.
-
 Article
ArticleAdvancing microbiome innovation
In the fourth instalment of EPR's ‘Microbiome therapeutics: microscope to medicine’ series, Emilie Plantamura, Deputy Chief Medical Officer at MaaT Pharma, examines the promising potential of microbiome therapeutics beyond Clostridium difficile infection, particularly in the onco-haematological field.
-
 News
NewsInnovative personalised immunotherapy approved for multiple myeloma
Approval of the cell therapy by the US FDA could provide a treatment-free respite as early as first relapse for patients with multiple myeloma.
-
 News
NewsPreventative approach could reduce immunotherapy side effects
Research suggests that giving prophylactic treatment prior to immunotherapy could eliminate the need for the latter to be administered in hospitals.
-
 News
NewsAstraZeneca to advance haematology cell therapy
The new acquisition grants AstraZeneca rights to a new CAR-T cell therapy with a differentiated manufacturing process that could provide a potential best-in-class blood cancer treatment.
-
News
NewsPhase III data for novel telomerase inhibitor released
Currently, imetelstat is being reviewed by the FDA and EMA for the treatment of transfusion-dependent anaemia in adults with lower risk MDS.
-
 News
NewsBRUKINSA® granted significant EU approval in follicular lymphoma
The first and only Bruton’s tyrosine kinase (BTK) inhibitor approved for follicular lymphoma in the EU, now has the broadest label of any medicine in its class globally.
-
 News
NewsCould GSK myelofibrosis treatment gain EU-first approval?
If approved, momelotinib will be the first treatment in the EU indicated for myelofibrosis patients with moderate to severe anaemia.



